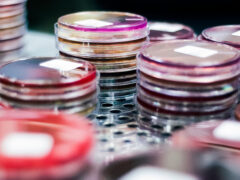
Auger Plates on metal cart

Diabetes Tipo 1 (ES)
¿Qué es la diabetes? La diabetes es una enfermedad que se produce cuando el cuerpo no puede regular adecuadamente el azúcar en la sangre. Esto ocurre cuando el cuerpo no produce insulina o no puede...

Fisuras Anales
¿Qué son las fisuras anales? Una fisura anal es una pequeña grieta o desgarro en el revestimiento delgado y húmedo de la parte inferior del recto. Es una afección muy común. A veces, las personas c...

Enfermedad de Alzheimer
¿Qué es la enfermedad de Alzheimer? La enfermedad de Alzheimer es un tipo de demencia. La demencia es una afección que describe una amplia gama de síntomas. Los síntomas están asociados con cambios...

Accidente cerebrovascular
¿Qué es el accidente cerebrovascular? El accidente cerebrovascular es una afección médica. Ocurre cuando se detiene el flujo de sangre que va a su cerebro. Cuando esto sucede, hace que sus células ...
Clostridium difficile (C. diff.) Infección
¿Qué es la infección por clostridium difficile (C. diff.)? El clostridium difficile (C. diff.) es un tipo de bacteria que vive en el intestino de muchas personas. El C...

Colesterol Alto
¿Qué es el colesterol alto? El colesterol es una sustancia cerosa que su hígado produce para proteger los nervios y producir tejido celular y ciertas hormonas. Su cuerpo también...

Disfunción eréctil
¿Qué es la disfunción eréctil? La disfunción eréctil (DE) es cuando un hombre no puede tener o mantener una erección. La afección evita que el hombre tenga relaciones sexuales o que las termine. Es...

Demencia (ES)
¿Qué es la demencia? La demencia no es una enfermedad. La demencia es un grupo de síntomas que pueden ser causados por un daño cerebral. La demencia a menudo ocurre en personas mayores. Sin embargo...



